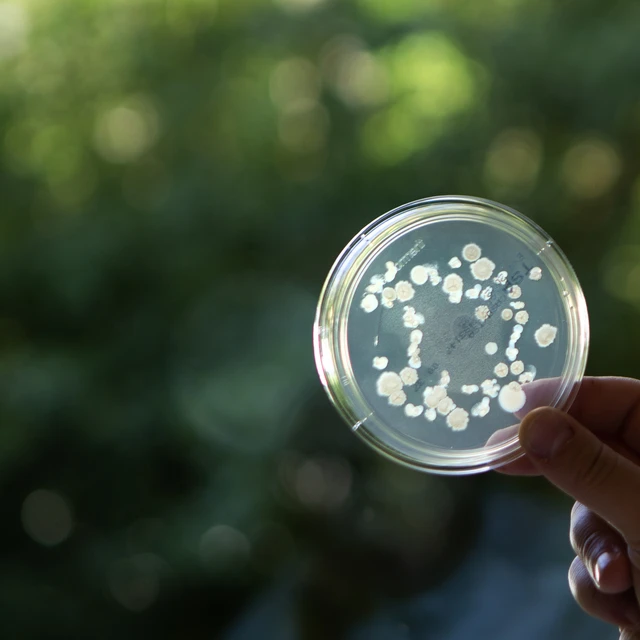
Plant Health_Formulation Lab_petridish

Our values and commitment in procurement
At Novonesis, we are committed to fostering strong partnerships, driving sustainability and promoting innovation through our procurement practices. We strive for excellence, transparency and collaboration in everything we do — ensuring that our sourcing decisions create value not just for our business, but for our partners and the planet.
Why partner with us?
By choosing Novonesis, you are partnering with a company that values responsible sourcing, cutting-edge technology and strategic supplier relationships. Additionally, you gain an exceptional chance for collaboration with a global company operating in North America, Latin America, India, Europe, the Middle East & Africa and the Asia Pacific regions.
We are a proud member of the ‘Together for Sustainability’ (TfS) industry initiative and a champion of the ‘Sustainable Procurement Program’ (SPP), affirming our commitment to responsible sourcing and sustainable practices.
Driving success together
We work closely with our suppliers to foster mutual growth and long-term value. Our focus goes beyond transparency and cost-efficiency — we’re committed to minimizing environmental impact and actively mitigating supply risks. By collaborating early and often, we build resilient and agile supply chains that can adapt to change and deliver high-quality biosolutions to our customers worldwide. Join us in shaping a better future through sustainable procurement. You’ll become part of our dynamic network of forward-thinking partners.

Supplier management
Trusted supplier collaboration is a key part of how we operate at Novonesis. Our approach to supplier management is guided by our core values of integrity, openness and innovation. We apply these values through structured category management to help us navigate shared challenges, unlock opportunities and build more sustainable supply chains — together.
We regularly engage with our suppliers to review performance and identify areas for improvement. These reviews are not just checkpoints — they’re opportunities for dialogue, learning and mutual growth. Through open communication and joint planning, we aim to build resilient, long-term partnerships that benefit both sides.

Category management
Our category management is a strategic lever that connects what we source to the biosolutions we deliver. It’s not just about optimizing costs — it’s about maximizing value across our supply chains. By aligning closely with our commercial and sales categories, we ensure that procurement decisions directly support the innovation, quality and sustainability our customers expect. Our approach is grounded in deep analysis of market dynamics, supplier capabilities and internal needs. From there, we develop tailored strategies for each category that drive performance, resilience and long-term impact. This integrated view helps us build stronger supplier partnerships and deliver biosolutions that make a difference.
Categories:
- Agriculture
- Chemicals
- Utilities
- Contract Manufacturing Organizations (CMO)
- Process Aids
- Dairy
- Facility Services
- Research and Lab Supplies
- Consulting, Professional & Financial and Legal Services
- IT, Software & Digital Technology
- Maintenance, Repair & Operations
- Marketing and Creative Services
- Human Resource Services
- Business Travel Services
- Engineering and related consultants (Investments)
- Transport & Warehousing
Financial information
At Novonesis, we leverage advanced e-sourcing and e-auction platforms to streamline our procurement processes and enhance supplier engagement. Our e-sourcing tools enable us to conduct efficient and transparent sourcing events, from initial supplier identification to final contract award. Through e-auctions, we foster competitive bidding among suppliers and get the best value for our organization. These digital solutions not only improve cost efficiency but also promote fairness and transparency in our supplier selection process.
Our five e-auction principles ensure that the auctions are effective and comply with business ethics.
- Competition: We apply e-auctions when meaningful competition is possible and appropriate.
- Awarding: We develop awarding principles prior to the e-auction and share them with suppliers.
- Honoring: Novonesis will honor the outcome of the e-auction in accordance with the awarding principles.
- Qualification: We pre-qualify invited suppliers, ensuring they have a fair chance of winning the business.
- Non-price: Whenever possible, we include a value model that incorporates non-price factors.
At Novonesis, we adhere to strict invoicing and purchasing guidelines. This is to ensure efficiency, transparency and compliance across our procurement processes. All purchases must be backed by a valid purchase order (PO) issued by our procurement team. Our "No PO, No Pay" policy means that invoices received without a corresponding PO will not be processed for payment. This policy helps us maintain control over our expenditures, ensure accurate financial tracking, and foster strong supplier relationships.
Invoices directed to Novonesis must be submitted within two days of generation and should always contain the following details:
- The top of the invoice must list the Novonesis legal entity, including the correct legal name and address of the applicable Novonesis company.
- Invoices should be labeled Attention: "Accounts Payable".
- Include the invoice date, invoice number, description of the delivery, invoice amount, and VAT or tax amount.
- A Novonesis reference must be provided, which can include:
- A Novonesis 10-digit purchase order number, OR
- The full name and initials of a Novonesis contact person.
- The supplier's company name, address, and VAT number or Federal Tax ID must be included.
- Bank information for wire Automated Clearing House (ACH) payments from the supplier should be provided.
• In China, it is essential that the invoice is a "fapiao"; otherwise, the expense will not be tax-deductible in the country.
We strive to maintain competitive and fair supplier payment terms for mutual growth and success. Our standard payment terms are 90+ days, from valid receipt of invoice or receipt of Products/Services if later - except as otherwise specified in the Agreement or if restricted under local legal requirement. This gives us the financial flexibility to reinvest in innovation and sustainability initiatives. We adhere to local legal requirements and negotiate terms that are mutually beneficial, fostering strong and transparent relationships with our suppliers. By maintaining clear communication and respecting the needs of our suppliers, we aim to create a collaborative and efficient supply chain.
| North America | PO BOX 576 77 Perrys Chapel Church Road Franklinton NC 27525 USA |
| Latin America | Rua Professor Francisco Ribeiro 683 83707-660 Araucária - PR Brazil |
| India | Plot No. 32, 47-50, EPIP Area Bangalore, Karnataka 560066 India |
| Europe, Middle East & Africa | Kogle Allé 6 2970 Hoersholm Denmark |
| Asia Pacific | 150 NanHai Road TEDA 300457 Tianjin P.R. China |
Sustainability in procurement
At Novonesis, sustainability is a natural part of our procurement DNA. We work towards a sustainable and responsible supply chain, working collaboratively with our suppliers as well as making it a part of the end-to-end procurement process. To ensure alignment with the Novonesis goals and ensure that the way we conduct business with our suppliers is in line with environmental, social and ethical standards, all supply chain partners are expected to uphold our Business Partner Code of Conduct.
Climate action
Battling climate change is one of the biggest challenges of our time, and Novonesis has set an ambitious target of reducing its Scope 3 emissions with 35% by 2030, compared to 2018 levels.
We can’t do this alone; partnering with suppliers will be instrumental in the decarbonization journey. Through our Supplier Climate Engagement Program called PAVE to Zero, we invite our suppliers to join our journey to jointly reduce the environmental footprint of our businesses. The program is designed to have targeted engagement with our suppliers, with clear expectations as follows:
Three defined expectations towards our suppliers:
1. Take climate action
Novonesis suppliers will be expected to:
- Measure and disclose emissions
- Set GHG reduction targets
- Adopt renewable energy
2. Disclose emissions and other ESG data
Our suppliers should:
- Share Product Carbon Footprint or emission data associated with Novonesis supply
- ESG data disclosure for risk assessment
3. Collaborate on reduction initiatives
Collaborate with us to deliver low-carbon products, such through:
- Green, low carbon alternatives
- Optimization
- Innovation
Read more about Novonesis Environmental goals
Responsible sourcing
Novonesis is a signatory to the UN Global Compact and the UN Guiding Principles on Business and Human Rights, and we conduct our activities in accordance with the OECD Guidelines for Multinational Enterprises. The Responsible Sourcing programme aims to mitigate sustainability risks by evaluating our suppliers' ESG performance as well as addressing their improvement areas. Sourcing strategies are developed in Procurement taking into account spend, country, category risk and performance aiding in the selection and evaluation of our business relationships.
To further drive our own and our suppliers' sustainability performance, Novonesis joined the Together for Sustainability industry initiative, which is building a global standard for environmental, social and governance performance. Our suppliers are screened, assessed and monitored based on a risk-based methodology either via tools, desktop assessments and/or onsite audits with a corrective action plan to improve their performance.

Sustainable procurement partnerships
Novonesis is a sponsor and member of cross-industry sustainable procurement collaborations shaping industry best practices and knowledge sharing.

SPP Champion

Together for Sustainability member

Scope 3 peer group participant